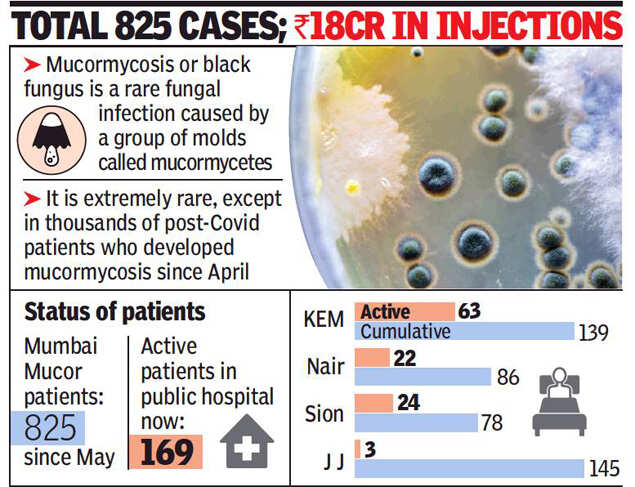

MUMBAI: Mucormycosis, the fungal infection that swept through the country in the May-June period, saw 825 post-Covid patients needing admission to various city hospitals and specialised injections costing over Rs 18 crore.
Around 20% of these patients died due to complications, and about two-thirds of them hailed from outside Mumbai.
While the “mucor crisis” is ebbing with barely one or two new admissions on some days, 169 patients are still admitted in various civic and state government hospitals for the injections that are given free. Each patients needs six vials of the injection for 25 days.
“Since May 25, KEM Hospital, as the nodal centre in the city, recieved and distributed 31,248 vials of amphotericin B to the patients registered in the city,” said KEM Hospital dean Dr Hemant Deshmukh.
Data available for 806 patients till last week showed 237 were from Mumbai while 569 were from outside the city.
“Roughly 30% of the patients were from Mumbai,” said Dr Deshmukh.
Studies done on mucormycosis patients in the past three months showed that most of them had diabetes and had received steroids as part of their Covid treatment.
“We have found that each patient needed one to three surgeries but some with residual infection are still getting admitted to public hospitals,” said Dr Deshmukh. As private hospitals charge over Rs 20 lakh for the entire treatment, including surgeries, some patients sought admissions to public hospitals such as KEM after undergoing partial treatment in the private sector.
Several public hospitals also used the conventional amphotericin B, which costs a fraction of the newer one, for younger patients.
“If we found that someone had higher creatinine (an indicator of kidney function) levels, then we would change them to the liposomal amphotericin B,” said the doctor.
Meanwhile, the central government released data on Tuesday showing that since May 11 it has distributed 8,14,323 vials of amphotericin (liposomal) to various states. Of these, Maharashtra got 1,52,770 injections.
The government also distributed 38,652 conventional amphotericin medicine; of these, 9,190 were given to Maharashtra.








